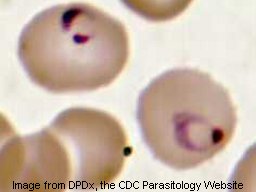
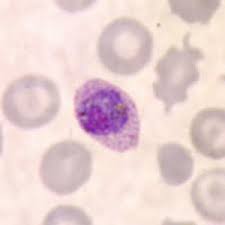
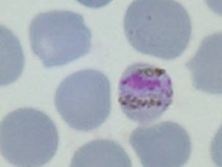

Malaria
Introduction.
Malaria is one of the world's
most
serious infectious diseases, causing over 1,000,000 deaths annually. It is
caused by protozoa of the genus Plasmodium, 4 of which
cause human disease: P. vivax, P. falciparum, P. ovale and P. malariae.
It is a vector-borne disease requiring the mosquito for part of the
pathogen's life cycle. Pathogenesis mainly involves lysis of red blood
cells and release of toxic cell contents.
Summary
- Cause: Plasmodium spp.
- Microscopy: Trophozoites
inside RBC (amoeboid),
merozoites
(elongated),
gametocytes
- Transmission: Anopheles mosquito (vector-borne)
- Life
cycle
- Symptoms: initially flu-like (headache, aches, nausea) then chills
& fever recurring every 24 - 72 hours. Attacks may be mild or severe
- Complications: chronic infections; toxic cell byproducts, blood
clumping, kidney failure (blackwater fever)
- Pathogenesis: Infection of liver cells and red blood cells; lysis
of RBCs causing anemia and releasing toxic compounds.
- Treatment: Chloroquine, primaquine (prevent relapses), quinine
- Plasmodium vivax
- Ring-shaped trophozoite, enlarged RBC, round gametocyte
- 48 hr fever/chills, Untreated infection lasting years
- Liver infected; relapses common (hypnozoites)
- Most prevalent worldwide
-
Plasmodium
ovale
- Oval trophozoite, enlarged RBC, oval gametocyte
- 48 hr fever/chills, Untreated infections last ~ 1 year
- Liver infected; relapses common (hypnozoites)
- Most prevalent in tropical Africa
-
Plasmodium
malariae
- Band and bar forms in RBC; normal size RBC
- 72 hour fever/chill pattern; Untreated infections may last 20 years
- Does not have relapses
- Plasmodium
falciparum
- Multiple ring-shaped trophozoites, banana-shaped gametocyte, normal size RBC
- Initially 24 hr periodicity; Untreated infections most likely to be
lethal
- Tropical and subtropical
- many chloroquine-resistant strains; blackwater fever
- Plasmodium knowlesi
- ring-shaped trophozoites, normal size RBC
- 24 hr periodicity
- Asia (esp. Malaysia)

- Monkey reservoir - macaques